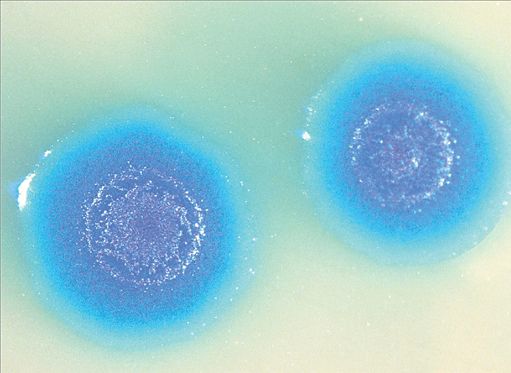

Ζωή…εργαστηρίου
Ζωή στο εργαστήριο συνέθεσαν ο αμφιλεγόμενος γενετιστής Κρεγκ Βέντερ, ο οποίος έγινε ευρέως γνωστός πριν από 10 χρόνια χάρη στη συμμετοχή του στην αποκωδικοποίηση του ανθρωπίνου γονιδιώματος, και οι συνεργάτες του από το Ινστιτούτο J. Craig Venter στις ΗΠΑ. Οι ερευνητές ανακοίνωσαν με δημοσίευσή τους στην έγκριτη επιθεώρηση «Science» ότι επέτυχαν τη «γέννηση» του πρώτου ζωντανού κυττάρου το οποίο λειτουργεί με βάση συνθετικό DΝΑ. Σύμφωνα με δηλώσεις του ίδιου του Βέντερ η ομάδα δημιούργησε «το πρώτο είδος στον πλανήτη που μπορεί να πολλαπλασιάζεται και το οποίο έχει για γονέα έναν…
υπολογιστή».
Οι ερευνητές ουσιαστικώς…
κατασκεύασαν ολόκληρο το «γενετικό λογισμικό» ενός βακτηρίου και το μεταμόσχευσαν σε ένα άλλο βακτήριο. Τι προέκυψε από αυτή τη μεταμόσχευση; Ζωή από το… τίποτα. Το μικρόβιο στο οποίο μεταμοσχεύθηκε το «γενετικό λογισμικό» εργαστηρίου έμοιαζε τόσο στη μορφή όσο και στη συμπεριφορά με το είδος στο οποίο ανήκε το συνθετικό DΝΑ.
Το επίτευγμα αυτό, για την πραγματοποίηση του οποίου απασχολήθηκαν 20 επιστήμονες για περισσότερα από 10 χρόνια και δαπανήθηκαν περί τα 40 εκατομμύρια δολάρια, χαρακτηρίστηκε από κάποιους ένα σημαντικό βήμα προς τη δημιουργία πιο σύνθετων τεχνητών οργανισμών οι οποίοι κάποια ημέρα θα παράγουν νέα καύσιμα, θα απορροφούν τα αέρια του θερμοκηπίου και θα επιταχύνουν την παραγωγή εμβολίων. Υπήρξαν όμως και οι επικριτές που ανέφεραν ότι ο Βέντερ προσπαθεί να παραστήσει τον Θεό και ότι δεν σκέφτεται το κόστος από την έκλυση νέων οργανισμών στο περιβάλλον. Σύμφωνα με τους αντιδρώντες αν τεχνητοί οργανισμοί «δραπετεύσουν» στη φύση θα μπορούσαν να προκαλέσουν ένα περιβαλλοντικό χάος ή να μετατραπούν σε βιολογικά όπλα. Ο ίδιος ο Βέντερ υπεραμυνόμενος της προσπάθειάς του ανέφερε ότι οι τεχνητοί οργανισμοί που δημιουργεί θα έχουν μόνο εμπορικές χρήσεις για το καλό της ανθρωπότητας και όχι το «σατανικό» καθήκον να υποκαταστήσουν τη ζωή έτσι όπως την ξέρουμε.
Ο νέος οργανισμός που δημιουργήθηκε διαθέτει μια τεχνητή εκδοχή του DΝΑ ενός υπάρχοντος βακτηρίουΜycoplasma mycoides- το οποίο προκαλεί μαστίτιδα στις αίγες. Το τεχνητό γονιδίωμα που προέκυψε εισήχθη σε ένα άλλο βακτήριο-λήπτη, του είδους Μycoplasma capricolum, από το οποίο προηγουμένως είχε αφαιρεθεί το γενετικό υλικό. Για να δημιουργήσουν το «λογισμικό» του κυττάρου οι επιστήμονες αντέγραψαν αρχικώς το υπάρχον βακτηριακό γονιδίωμα και κατέγραψαν την αλληλουχία του γενετικού κώδικά του. Στη συνέχεια με ειδικά μηχανήματα χημικής σύνθεσης δημιούργησαν ένα αντίγραφο του κώδικα. Ο τεχνητός αυτός γενετικός κώδικας μεταμοσχεύθηκε στο δεύτερο βακτηριακό κύτταρο.
Μόλις το νέο «λογισμικό» εισήλθε εντός του κυττάρουλήπτη, το κύτταρο «διάβασε» το λογισμικό και μετετράπη στο είδος που ορίζει ο γενετικός κώδικας. Ο οργανισμός που προέκυψε πολλαπλασιάστηκε μάλιστα για περισσότερες από ένα δισεκατομμύριο φορές, παράγοντας αντίγραφα που έφεραν το τεχνητό DΝΑ.
Σύμφωνα με δηλώσεις του δρος Βέντερ στο ΒΒC τα νέα βακτήρια… εργαστηρίου θα σημάνουν μια καινούργια «βιομηχανική επανάσταση».
Μάλιστα, όπως είπε ο γενετιστής, η ερευνητική ομάδα βρίσκεται ήδη σε συνεργασία με φαρμακευτικές εταιρείες και εταιρείες παραγωγής καυσίμων με στόχο τον σχεδιασμό χρωμοσωμάτων βακτηρίων τα οποία θα σημάνουν μια νέα εποχή στη βιομηχανία.
Οι επικρίσεις βέβαια δεν έλειψαν στο άκουσμα της νέας είδησης. Δεν ήταν λίγοι εκείνοι που σημείωσαν ότι μόνος στόχος του Βέντερ είναι να κάνει εμπόριο με βάση τους νέους αυτούς οργανισμούς. Σε κάθε περίπτωση ένα είναι το σίγουρο: ο Βέντερ έχει αποδείξει εδώ και χρόνια με τις έρευνές του (εκτός από την αποκωδικοποίηση του γονιδιώματος πριν από μερικά χρόνια δημιούργησε και τον πρώτο συνθετικό ιό εργαστηρίου προκαλώντας συζητήσεις σχετικά με το πόσο ηθικές είναι τέτοιες έρευνες ακόμη και στον Λευκό Οίκο)
ότι ξέρει να τραβά επάνω του τα φώτα της δημοσιότητας…
Εισπνεόμενο «ταχείας στύσεως»
Η βρετανική εταιρεία Vectura, που ειδικεύεται στη δημιουργία συσκευών εισπνοής για διάφορες χρήσεις, ολοκλήρωσε τις δοκιμές μιας νέας συσκευής εισπνοής η οποία υπόσχεται άμεση λύση στο πρόβλημα της στυτικής δυσλειτουργίας. Σύμφωνα με την εταιρεία, η νέα συσκευή επιτυγχάνει το επιθυμητό αποτέλεσμα μέσα σε διάστημα μόλις δέκα λεπτών. Η συσκευή περιέχει σε μορφή σκόνης την ουσία απομορφίνη η οποία έχει δείξει σε προηγούμενες έρευνες ότι έχει πολύ θετική δράση απέναντι στο συγκεκριμένο πρόβλημα. Στην έρευνα έλαβαν μέρος 600 ασθενείς και η συσκευή λειτούργησε αποτελεσματικά μέσα σε διάστημα δέκα λεπτών στη συντριπτική πλειονότητα εξ αυτών. Δυσάρεστα είναι όμως τα ευρήματα άλλης έρευνας που μελέτησε τις παρενέργειες της κατανάλωσης των φαρμάκων κατά της ανδρικής ανικανότητας όπως το Viagra, το Cialis και το Levitra. Επιστήμονες της Σχολής Δημόσιας Υγείας του Πανεπιστημίου του Μπέρμιγχαμ διαπίστωσαν ότι η κατανάλωση αυτών των φαρμάκων πολλαπλασιάζει τον κίνδυνο απώλειας της ακοής.
Κλιματικές αλλαγές εναντίον ωκεανών
Επιστήμονες της Εθνικής Υπηρεσίας Ωκεανών και Ατμόσφαιρας (ΝΟΑΑ) των ΗΠΑ αναφέρουν ότι η θερμοκρασία των υδάτων αυξάνεται αξιοσημείωτα και μάλιστα όχι μόνο κοντά στην επιφάνεια αλλά και σε βάθη εκατοντάδων μέτρων. Οι μεταβολές στη θερμοκρασία και στην οξύτητα των υδάτων ακολουθούνται και από άνοδο της στάθμης των υδάτων. Η αύξηση της θερμοκρασίας και της οξύτητας επί της ουσίας προκαλεί φαινόμενα ασφυξίας και δηλητηρίασης για τα θαλάσσια οικοσυστήματα, ενώ η αύξηση των επιπέδων των υδάτων θα έχει αποτέλεσμα να υπάρξουν εκτεταμένες πλημμύρες σε νησιωτικές και παράκτιες περιοχές του πλανήτη.
Τα ευρήματα της ΝΟΑΑ είναι σύμφωνα και με αυτά του Ευρωπαϊκού Ιδρύματος Επιστήμης, το πόρισμα του οποίου αναφέρει χαρακτηριστικά ότι «οι ωκεανοί παρουσιάζουν σήμερα τη μεγαλύτερη οξύτητα των τελευταίων 20 εκατομμυρίων ετών». Σύμφωνα με το πόρισμα, οι ωκεανοί και οι θάλασσες του πλανήτη στο τέλος του αιώνα θα είναι 150% πιο όξινοι απ΄ όσο ήταν κατά την προβιομηχανική περίοδο.